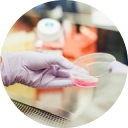

YOE YAR ရဲ့ အရည်အချင်းပြည့်ဝသေ ဆေးဝါးပညာရှင်များက သင့်ကို အကောင် ဆုံးဝန်ဆောင်မှုများ ပေးမှာဖြစ်ပါတယ်။
provided by health educated persons

အသိညဏ်နဲ့ အတတ်ပညာ အခြေပြုထားတဲ့ ကျန်းမာရေး စောင့်ရှောက်မှုကို သင့်တင့်တဲ့ အဖိုးအခနဲ့ လွယ်လွယ်ကူကူ ရယူနိုင်မယ်။